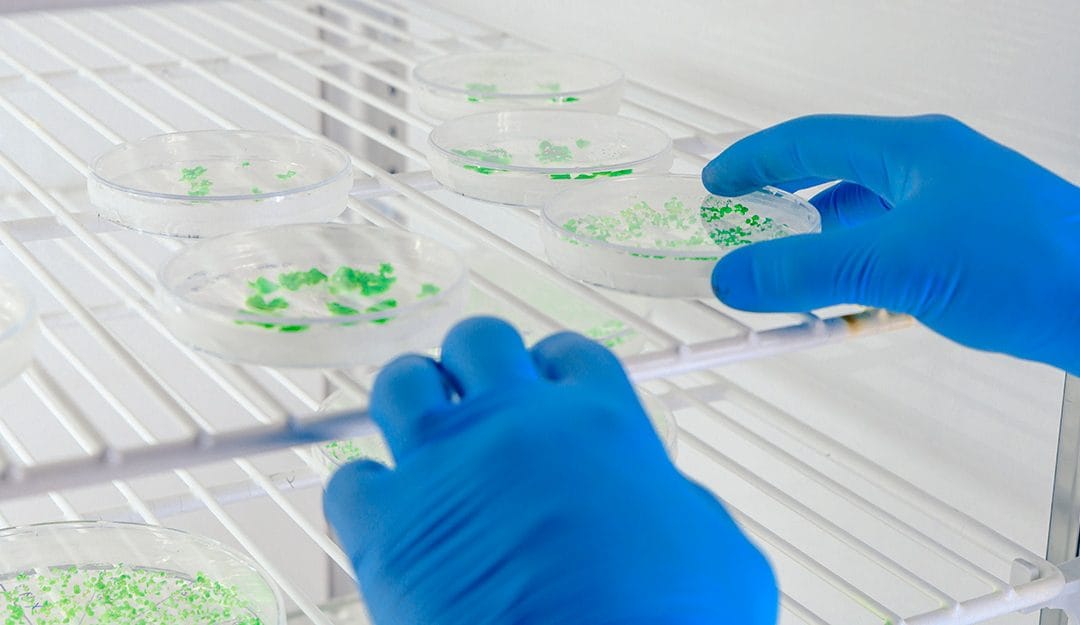
Control y desinfección de Legionella en Vigo

La esterilidad en un entorno quirúrgico no es negociable. En instalaciones donde la seguridad del paciente depende de la ausencia total de patógenos, el control de plagas y la desinfección de alto nivel son los pilares fundamentales de la gestión sanitaria...